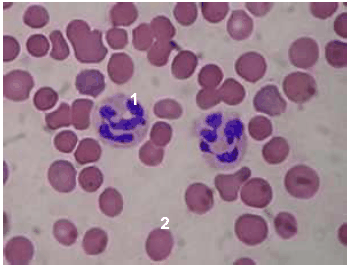
Enunciado 3896570-1

Foram encontradas 1.660 questões.
Num dado circuito, quando um diodo está polarizado diretamente, sua corrente é de 50 mA. Quando polarizado reversamente, a corrente cai para 250 nA. A razão entre a corrente direta e a reversa é aproximadamente:
Provas
Numa residência estão ligadas cinco lâmpadas de 100 W, um ferro elétrico de 1.000 W e uma geladeira que consome 300 W. A diferença de potencial na rede é de 220 V.
A corrente total que está sendo fornecida para essa casa é
Provas
Um homem de 20 anos de idade, com suspeita clínica de tuberculose, foi ao laboratório com uma requisição de exame para realização da baciloscopia. Considerando a requisição, o técnico do laboratório orientou o paciente quanto à coleta do material necessário à realização do exame.
Nesse caso, o procedimento correto para a obtenção do material biológico a ser examinado é o seguinte:
Provas
Nas técnicas microbiológicas, os processos de inoculação de microrganismos são diversificados e dependem do objetivo que se queira atingir com a semeadura.
Considere as afirmações a seguir, sobre técnicas de inoculação de microrganismos e seus respectivos objetivos.
| I |
A técnica de esgotamento por meio de estrias superficiais é usada principalmente para se obter o crescimento em massa de microrganismos. |
| II |
A técnica de semeadura em superfície é utilizada em testes para sensibilidade a antimicrobianos. |
| III |
O método de pour-plate é bastante utilizado em técnicas de contagem microbiana. |
| IV |
Em todas as técnicas de inoculação, o objetivo é diminuir-se a população microbiana, possibilitando-se que colônias de mesma origem estejam localizadas a uma certa distância umas das outras. |
As afirmativas corretas são
Provas
O ágar Müeller-Hinton é o meio de primeira escolha para testes rotineiros de sensibilidade a antimicrobianos. Entretanto, esse meio não é adequado quando é necessário testar a sensibilidade de organismos
Provas
Os níveis de biossegurança são designados em ordem crescente, pelo grau de proteção proporcionado ao pessoal do laboratório, ao ambiente e à comunidade.
Considere as afirmações a seguir, relacionadas ao nível de biossegurança 2:
| I | O trabalho é realizado com agentes de risco moderado. |
| II | O risco potencial de produção de borrifos e aerossóis é alto. |
| III | O vírus da heptite B, a salmonela e o vírus HIV são organismos designados para esse tipo de contenção. |
| IV | É adequado para qualquer trabalho que envolva sangue humano, líquidos corporais, tecidos ou linhagens de células humanas primárias em que a presença de um agente infeccioso possa ser desconhecida. |
O conjunto de todas as afirmativas corretas está expresso em
Provas
Um padrão de glicose contém 10mg de glicose/mL. Ao fazer-se uma diluição 1/50 desse padrão, a quantidade de glicose, por mililitro, é
Provas
A figura abaixo representa uma lâmina referente a um hemograma.
Na figura, os números 1 e 2 correspondem, respectivamente, a
Provas
Considere uma requisição de exames com as seguintes especificações:
- Identificação: J.P.S., 25 anos de idade, sexo masculino;
- Sinais clínicos: febre, dor de cabeça, manchas vermelhas na pele
- Exames solicitados: pesquisa de anticorpos contra o vírus da dengue, hemograma e contagem de plaquetas.
Para a realização dos exames solicitados, é correto afirmar:
Provas
Para a realização dos testes sorológicos de aglutinação é comum fazerem-se diferentes diluições do soro e manterem-se constantes as quantidades de antígeno. Esse procedimento visa
Provas
Caderno Container